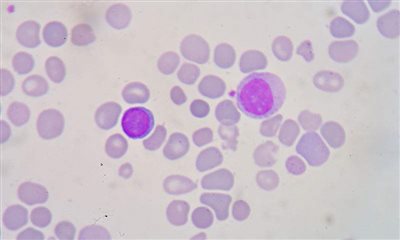

Μεσογειακή αναιμία: Ελπίδες για ίαση χάρη σε νέα γενετική μέθοδο
Επιστήμονες στις ΗΠΑ χρησιμοποίησαν μια νέα τεχνική τροποποίησης του γονιδιώματος, με την οποία θεράπευσαν σε ποντίκια τη β-θαλασσαιμία, γνωστή και ως μεσογειακή αναιμία.
Πρόκειται για μια κληρονομική νόσο του αίματος, η οποία συνεπάγεται μείωση στην παραγωγή της αιμοσφαιρίνης, με αποτέλεσμα να προκαλείται έλλειψη οξυγόνου στο σώμα, πράγμα που έχει ποικίλες συνέπειες όπως ωχρό δέρμα, αδυναμία, κόπωση ή και πιο σοβαρές επιπλοκές.
Οι ερευνητές των πανεπιστημίων Γέιλ και Κάρνεγκι Μέλον, με επικεφαλής τον καθηγητή Πίτερ Γκλέιζερ, οι οποίοι έκαναν τη σχετική δημοσίευση στο περιοδικό Nature Communications, ανέπτυξαν μια νέα, ελάχιστα επεμβατική στρατηγική για τη διόρθωση των μεταλλάξεων που προκαλούν τη θαλασσαιμία.
Οι ερευνητές χρησιμοποίησαν ένα καινοτόμο συνδυασμό από νανοσωματίδια, συνθετικά τμήματα DNA και ενδοφλέβια έγχυση. Η τεχνική θεράπευσε τα πειραματόζωα από την εν λόγω μορφή αναιμίας.
Παρότι το ποσοστό επιτυχίας ήταν γύρω στο 7%, όσον αφορά την επιτυχή γενετική διόρθωση στα αιματοποιητικά βλαστικύτταρα αυτό ήταν αρκετό για να εξαφανιστεί η αναιμία. Τα ποντίκια δεν είχαν πια καθόλου συμπτώματα της νόσου και έπειτα από πέντε μήνες τα επίπεδα της αιμοσφαιρίνης στο αίμα τους ήταν φυσιολογικά.
Το επίτευγμα ανοίγει τον δρόμο για την εφαρμογή της νέας γενετικής τεχνικής στους ανθρώπους. Οι γιατροί ελπίζουν ότι θα καταφέρουν με τη βοήθεια της γενετικής να θεραπεύσουν τις κληρονομικές διαταραχές του αίματος, όπως η θαλασσαιμία και η δρεπανοκυτταρική αναιμία.
Οι Αμερικανοί επιστήμονες πήραν από το μυελό των οστών μια πρωτεΐνη που ενεργοποιεί τα βλαστικά κύτταρα του αίματος και τη συνδύασαν με συνθετικά μόρια (πεπτίδια νουκλεϊκού οξέος, γνωστά ως ΡΝΑ) που μιμούνται το DNA και προσκολλώνται στο ελαττωματικό γονίδιο-στόχο ΗΒΒ. Αυτό πυροδοτεί μέσα στο κύτταρο που παράγει το αίμα μια διαδικασία αυτοδιόρθωσης της παθογόνου μετάλλαξης. Η μεταφορά των μορίων ΡΝΑ γίνεται μέσω βιοσυμβατών νανοσωματιδίων, τα οποία εισάγονται στο σώμα με ενδοφλέβια ένεση.
Ο Π. Γκλέιζερ ανέφερε ότι η νέα μέθοδος είναι ανώτερη από εναλλακτικές γενετικές τεχνικές, όπως για παράδειγμα η ανταγωνιστική CRISPR, η οποία μπορεί να έχει ανεπιθύμητες παρενέργειες, όπως η μετάλλαξη κάποιου άσχετου γονιδίου.
Αν η τεχνική αποδειχθεί όντως αποτελεσματική και στις μελλοντικές κλινικές δοκιμές σε άλλα ζώα, μπορεί τελικά να οδηγήσει στη θεραπεία της μεσογειακής αναιμίας στους ανθρώπους –και πιθανώς και άλλων αιματολογικών διαταραχών όπως η δρεπανοκυτταρική αναιμία. Θα χρειαστούν όμως χρόνια εωσότου υπάρξει οριστικό συμπέρασμα.
onmed